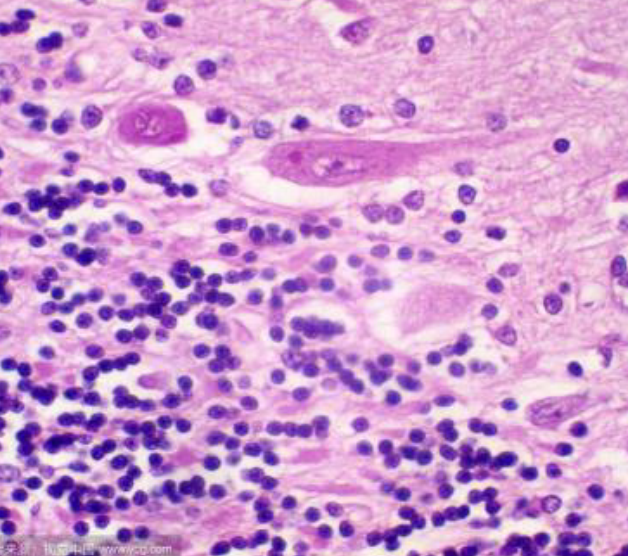
尼氏染色检测服务

万千商家帮你免费找货
0 人在求购买到急需产品
- 详细信息
- 文献和实验
- 技术资料
- 提供商:
上海达为科生物科技有限公司
- 服务名称:
尼氏染色检测
一、实验原理
Nissl染色液染色后呈蓝紫色,常用于显示脑或脊髓的基本神经结构。Nissl小体大而数量多,说明神经细胞合成蛋白质的功能较强;相反在神经细胞受到损伤时,Nissl小体的数量会减少甚至消失。Nissl染色液染色的有效成分是碱性染料焦油紫(Cresyl violet),又名jia酚紫和克紫,它可以和RNA或DNA结合,可以染色粗面型内质网上的核糖体,也可以染色细胞核。染色后使细胞体呈现斑驳的(mottled)蓝紫色染色。也可以用thionine (硫荲);tolridine blue (甲苯胺蓝)等碱性染料。
二、实验流程:
1.样本处理
2.尼氏染色:染色3-10分钟,蒸馏水洗涤2次(每次数秒钟即可),95%乙醇约5s
3.脱水、透明、封片
三、客户提供
样本
四、公司提供
图片,结果及分析。
实验周期:3-4周。
上海达为科生物科技有限公司,公司位于上海长江软件园,实验室面积600多平方米。我们拥有专业的实验室、先进的实验设备和经验丰富的科研技术人员。公司目前具备较好的生物学、医学技术服务平台,能够为广大客户提供医学科研样本检测、合作研究、开发及生产服务。
风险提示:丁香通仅作为第三方平台,为商家信息发布提供平台空间。用户咨询产品时请注意保护个人信息及财产安全,合理判断,谨慎选购商品,商家和用户对交易行为负责。对于医疗器械类产品,请先查证核实企业经营资质和医疗器械产品注册证情况。
 文献和实验
文献和实验成正比。 目前 ELISA 法应用 1、免疫酶染色各种细胞内成份的定位。 2、研究抗酶抗体的合成。 3、显现微量的免疫沉淀反应。 4、定量检测体液中抗原或抗体成份。 小优 ELISA 实验检测服务 优宁维公司提供空白板,buffer 缓冲液等 客户只需提供样本 小优结果形式:统计结果,实验流程,全程提供疑问解答 优宁维是专业的抗体公司,我们的实验服务团队是由博士后领衔的团队。我们实验室拥有先进的实验仪器平台,服务的价格是实惠亲民
先进的基于焦磷酸测序(Pyrosequencing)的PSQ96 MA技术平台,能提供基于序列测定的SNP检测、等位基因频率分析和甲基化检测服务。另外,还提供短片段的测序服务(50-100 bp),适用于细菌和病毒分型等研究领域。 基于Pyrosequencing的SNP分析具有快速、高通量的特点,完成96个样品的SNP分析仅需10分钟。整个实验过程(包括PCR扩增、单链分离、Pyrosequencing测序和数据分析)也只需3-4 小时。 PSQ96 MA配备有功能强大的SNP分析
和基础,它在整个与个人生老病死的生物产业链中起着基础性的作用,这就好比电信网络和设备是电信市场的基础一样。疾病易感基因检测使人们清楚预知自己可能得什么重大疾病,从而能提前进行预防,将彻底颠覆传统医院被动治疗的局面。因此,疾病易感基因检测的推广将拉开生物科技产业化的序幕。上海荣健生物技术有限公司经《中国人口健康基因检测科学社会工程》授权,是该工程首家“科普教育中心”和首家“就业培训基地”的承担单位,负责“主动健康™基因检测服务”产品的销售、推广、咨询、培训和服务等工作。服务采用的检测标准和服务标准











